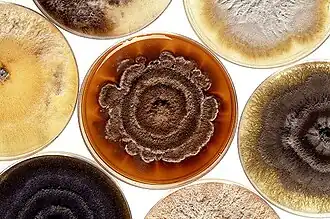
Phomopsis

Phomopsis
| Phomopsis | ||||||||||||
|---|---|---|---|---|---|---|---|---|---|---|---|---|
| ||||||||||||
| Taxonomische indeling | ||||||||||||
| ||||||||||||
| Geslacht | ||||||||||||
| Phomopsis Sacc. & Roum. (1884) | ||||||||||||
| Afbeeldingen op | ||||||||||||
| ||||||||||||
Phomopsis is een geslacht behorend tot de familie Diaporthaceae.
Soorten
Volgens Index Fungorum telt het 681 soorten (peildatum maart 2023):
| Soortnaam | Auteur(s) | Publicatiejaar |
|---|---|---|
| Phomopsis abrotani | (Oudem.) Sacc. & D. Sacc. | 1906 |
| Phomopsis abutilonis | Sacc. | 1915 |
| Phomopsis acaciae | C.C. Chen | 1967 |
| Phomopsis acaciicola | (Henn.) Died. | 1911 |
| Phomopsis acanthi | (Sacc. & D. Sacc.) Grove | 1920 |
| Phomopsis acerina | Pirone & J.C. Carter | 1966 |
| Phomopsis aceris | (Höhn.) Sacc. & D. Sacc. | 1906 |
| Phomopsis acmella | (Berk.) Petr. & Syd. | 1924 |
| Phomopsis adansoniae | Li Ma, P.K. Chi & Z.D. Jiang | 2004 |
| Phomopsis aesculana | (Sacc.) Petr. | 1921 |
| Phomopsis agapanthi | Punith. & Spooner | 2005 |
| Phomopsis agrostidis | Punith. & Spooner | 2002 |
| Phomopsis airae | Punith. & Spooner | 2002 |
| Phomopsis albolutea | (Dearn. & Barthol.) Petr. | 1929 |
| Phomopsis algerica | Maire | 1945 |
| Phomopsis alhagi | Woron. | 1915 |
| Phomopsis allamandae | Petr. | 1923 |
| Phomopsis allescheriana | (Henn.) Boerema, Loer. & Hamers | 1996 |
| Phomopsis almeidae | Traverso & Spessa | 1910 |
| Phomopsis alni-incanae | Sandu | 1964 |
| Phomopsis aloes-percrassae | Trinchieri | 1909 |
| Phomopsis alpiniae | Sousa da Câmara | 1949 |
| Phomopsis alsophilae | (Syd. & P. Syd.) Aa | 2002 |
| Phomopsis amaranthi | Ubrizsy & Vörös | 1966 |
| Phomopsis amazonica | (Syd. & P. Syd.) Aa | 2002 |
| Phomopsis amelanchieris | (Cooke) Grove | 1917 |
| Phomopsis amherstiae | Ponnappa | 1971 |
| Phomopsis ampelopsidis | Petr. | 1917 |
| Phomopsis amraii | M.P. Srivast., Tandon, Bhargava & A.K. Ghosh | 1966 |
| Phomopsis amygdaliana | Canonaco | 1936 |
| Phomopsis ananadis | M.M. Xiang & P.K. Chi | 1994 |
| Phomopsis ananasae | M.M. Xiang & P.K. Chi | 2000 |
| Phomopsis andina | Petr. | 1950 |
| Phomopsis annonae | Urries | 1952 |
| Phomopsis anthyllidicola | (Henn.) Died. | 1911 |
| Phomopsis antigoni | R.C. Rajak | 1981 |
| Phomopsis apocyni | Pisareva & Philim. | 1968 |
| Phomopsis aquifolii | (Brunaud) Keissl. | 1913 |
| Phomopsis aquilariae | Punith. & I.A.S. Gibson | 1978 |
| Phomopsis araliae | Koval | 1961 |
| Phomopsis araucariae | Grove | 1935 |
| Phomopsis archeri | B. Sutton | 1980 |
| Phomopsis arecae | Syd. & P. Syd. | 1914 |
| Phomopsis aristolochiae | Grove | 1917 |
| Phomopsis armeriae | Grove | 1930 |
| Phomopsis arnoldiae | B. Sutton | 1980 |
| Phomopsis artabotrydis | Syd. & P. Syd. | 1916 |
| Phomopsis arthrophylli | (Koord.) Aa | 2002 |
| Phomopsis artocarpi | Syd. | 1935 |
| Phomopsis asclepiadea | (Ellis & Everh.) Petr. | 1951 |
| Phomopsis asparagi | (Sacc.) Grove | 1935 |
| Phomopsis asparagicola | Alcalde | 1952 |
| Phomopsis asphodelina | (Thüm.) Traverso & Spessa | 1910 |
| Phomopsis asteriscus | (Berk & Broome) Grove | 1917 |
| Phomopsis aucubicola | (Brunaud) Grove | 1917 |
| Phomopsis avellana | Petr. | 1921 |
| Phomopsis baccharidis | Grove | 1935 |
| Phomopsis bakeri | Syd. & P. Syd. | 1913 |
| Phomopsis baliospermi | Suj. Singh & Kamal | 1979 |
| Phomopsis banksiae | Novoss. | 1936 |
| Phomopsis barbari | (Cooke) Punith. | 2002 |
| Phomopsis barringtoniae | Kamal & R.P. Singh | 1981 |
| Phomopsis batatas | (Ellis & Halst.) Harter & E.C. Field | 1912 |
| Phomopsis bauhiniae | Alcalde | 1952 |
| Phomopsis bauhiniicola | M.M. Xiang, Z.D. Jiang & P.K. Chi | 2003 |
| Phomopsis beckhausii | (Cooke) Traverso | 1906 |
| Phomopsis begoniae | Gutner | 1936 |
| Phomopsis berberina | (Sacc. & Roum.) Grove | 1919 |
| Phomopsis bertholletianum | E.R. Spencer | 1921 |
| Phomopsis bicincta | Syd. | 1926 |
| Phomopsis biformis | Bubák & Gonz. Frag. | 1915 |
| Phomopsis bignoniae | Curzi & Barbaini | 1927 |
| Phomopsis biwa | Hara | 1954 |
| Phomopsis bloxamii | Grove | 1917 |
| Phomopsis boehmeriae | Novoss. | 1936 |
| Phomopsis bossiaeae | (Henn.) Died. | 1911 |
| Phomopsis bougainvilleae | Sousa da Câmara | 1951 |
| Phomopsis brachyceras | Grove | 1935 |
| Phomopsis brachysematis | (Henn.) Died. | 1911 |
| Phomopsis brassicae | Sacc. & Roum. | 1884 |
| Phomopsis brencklei | Petr. | 1924 |
| Phomopsis brideliae | Chowdhry | 1966 |
| Phomopsis broussonetiae | (Sacc.) Died. | 1911 |
| Phomopsis brunaudiana | (Sacc.) B. Sutton | 1996 |
| Phomopsis brunaudii | (Pass.) Moesz | 1931 |
| Phomopsis bryophylli | Sousa da Câmara & A.T. Vasconc. | 1955 |
| Phomopsis buddlejae | Grove | 1930 |
| Phomopsis buettneriae | Bond.-Mont. | 1938 |
| Phomopsis buteae | V.P. Sahni | 1968 |
| Phomopsis buxi | (Desm.) Höhn. | 1920 |
| Phomopsis buxicola | P.K. Chi, C.Q. Chang & Z.D. Jiang | 2007 |
| Phomopsis cacti | (Berk.) Grove | 1917 |
| Phomopsis cajani | Syd. & P. Syd. | 1916 |
| Phomopsis calanthes | Sacc. | 1916 |
| Phomopsis callistephi | Tehon & E.Y. Daniels | 1925 |
| Phomopsis calophacae | (Henn.) Died. | 1911 |
| Phomopsis calotropidis | (Gonz. Frag. & Cif.) Petr. | 1929 |
| Phomopsis calystegiae | (Cooke) Grove | 1917 |
| Phomopsis camelliae-japonicae | Petr. | 1916 |
| Phomopsis campanulae-latifoliae | Petr. | 1925 |
| Phomopsis campomanesiae | Bond.-Mont. | 1936 |
| Phomopsis campsidis | M.T. Lucas & Sousa da Câmara | 1954 |
| Phomopsis canadensis | Bubák & Dearn. | 1916 |
| Phomopsis cancri | Punith. | 1974 |
| Phomopsis cannabina | Curzi | 1927 |
| Phomopsis caraganae | Bondartsev | 1922 |
| Phomopsis carludoviciae | Novoss. | 1936 |
| Phomopsis carnea | (Lib. ex Thüm.) Petr. | 1921 |
| Phomopsis carpogena | (Sacc. & Roum.) Died. | 1911 |
| Phomopsis carposchiza | Fairm. | 1921 |
| Phomopsis caryophylli | (Cooke) Grove | 1917 |
| Phomopsis caryotae-urentis | Petr. & Cif. | 1930 |
| Phomopsis cassiae | Sousa da Câmara | 1951 |
| Phomopsis cassiicola | M.M. Xiang, Z.D. Jiang & P.K. Chi | 2003 |
| Phomopsis castaneae | Woron. | 1915 |
| Phomopsis casuarinae | (Tassi) Died. | 1912 |
| Phomopsis catalpicola | Alcalde | 1952 |
| Phomopsis caulographa | (Durieu & Mont.) Grove | 1917 |
| Phomopsis cedrelae | Sousa da Câmara | 1932 |
| Phomopsis celastrinae | (Cooke) Bubák & Kabát | 1912 |
| Phomopsis celottii | (Sacc.) M.T. Lucas & Sousa da Câmara | 1952 |
| Phomopsis cephaelidis | (Bond.-Mont.) Aa & Vanev | 2002 |
| Phomopsis cephalotaxi | Sawada | 1950 |
| Phomopsis cestri | Syd. & P. Syd. | 1917 |
| Phomopsis chamaecristae | Petr. | 1952 |
| Phomopsis choisyae | Woron. | 1916 |
| Phomopsis chondrillae | (Hollós) Dias & M.T. Lucas | 1975 |
| Phomopsis christianicola | (Bat.) Vanev & Aa | 2002 |
| Phomopsis cichoracearum | (Sacc.) Bubák | 1906 |
| Phomopsis cinnamomi | S.M. Lin & P.K. Chi | 1992 |
| Phomopsis cinnamomicola | Z.D. Jiang, M.M. Xiang & P.K. Chi | 2003 |
| Phomopsis cirsii | Grove | 1935 |
| Phomopsis cistina | (Cooke) Grove | 1917 |
| Phomopsis citriodora | Grove | 1930 |
| Phomopsis cladrastidis | Petr. | 1934 |
| Phomopsis clarkiae | (Oudem.) Petr. | 1925 |
| Phomopsis clematidis | S. Ahmad | 1971 |
| Phomopsis clerodendri | Kamal & R.P. Singh | 1981 |
| Phomopsis clethrae | Novoss. | 1936 |
| Phomopsis clypeata | (Briard & Har.) Nannf. | 1939 |
| Phomopsis coccolobae | Sacc. | 1915 |
| Phomopsis cocculi | Maffei | 1916 |
| Phomopsis cocoes | Petch | 1922 |
| Phomopsis cocophila | (Speg.) Bond.-Mont. | 1936 |
| Phomopsis coffeae | Bond.-Mont. | 1936 |
| Phomopsis colae | Bond.-Mont. | 1936 |
| Phomopsis coluteae | (Sacc. & Roum.) Died. | 1911 |
| Phomopsis combreticola | Gutner | 1936 |
| Phomopsis commelinae | Punith. | 1975 |
| Phomopsis conii | Died. | 1915 |
| Phomopsis conspicua | Syd. & P. Syd. | 1920 |
| Phomopsis convallariae | (Westend.) Grove | 1921 |
| Phomopsis convolvulina | Petr. | 1925 |
| Phomopsis copelandii | Sacc. | 1917 |
| Phomopsis corchoricola | A.Z.M. Khan & S.K. Das | 1980 |
| Phomopsis cordiae | V. Nath & Bhargava | 1977 |
| Phomopsis cordifolia | (Brunaud) Died. | 1912 |
| Phomopsis cordylines | Ponnappa | 1971 |
| Phomopsis coriariicola | Speg. | 1910 |
| Phomopsis coronillae | (Westend.) Bubák | 1906 |
| Phomopsis correae | (McAlpine) Vanev | 2002 |
| Phomopsis corticis | (Fuckel) Grove | 1918 |
| Phomopsis corylopsidis | (Henn.) Died. | 1912 |
| Phomopsis corynocarpi | Sacc. | 1915 |
| Phomopsis crataegicola | Petr. | 1920 |
| Phomopsis crini | Chowdhry & D. Gupta | 1986 |
| Phomopsis crotalariae | G.F. Weber | 1933 |
| Phomopsis crotonophila | (Speg.) Aa | 2002 |
| Phomopsis cruciferae | Grove | 1917 |
| Phomopsis cunninghamii | Syd. | 1924 |
| Phomopsis cuscutae | H.C. Greene | 1964 |
| Phomopsis cuspariae | Gutner | 1933 |
| Phomopsis cyamopsidis | Petr. & Syd. | 1923 |
| Phomopsis cycadis | (Sacc. & Berl.) M.T. Lucas & Sousa da Câmara | 1954 |
| Phomopsis cyclobalanopsidis | (C.C. Chen) Vanev & Aa | 2002 |
| Phomopsis cydoniae | (Schulzer) Sacc. & Traverso | 1911 |
| Phomopsis cynanchi | (Sousa da Câmara) Sousa da Câmara | 1949 |
| Phomopsis cynanchicola | Petr. | 1931 |
| Phomopsis cynanchina | Petr. | 1922 |
| Phomopsis cytisi | Gonz. Frag. | 1914 |
| Phomopsis dahliae | Ponnappa | 1971 |
| Phomopsis dalbergiae | Sacc. | 1915 |
| Phomopsis daturicola | S. Ahmad | 1971 |
| Phomopsis dauci | Arx | 1951 |
| Phomopsis daucicola | Moesz | 1920 |
| Phomopsis dearnessiana | (Sacc.) Arx | 1957 |
| Phomopsis delogneana | Petr. | 1925 |
| Phomopsis dendrobii | V.G. Rao & B.R.D. Yadav | 1989 |
| Phomopsis desmazieri | (Durieu & Mont.) Grove | 1930 |
| Phomopsis destructa | D.P.C. Rao, S.C. Agarwal & S.B. Saksena | 1976 |
| Phomopsis detrusa | (Sacc.) Traverso | 1906 |
| Phomopsis deutziae | N.F. Buchw. | 1958 |
| Phomopsis diachenii | Sacc. | 1915 |
| Phomopsis dianthicola | Sacc. | 1915 |
| Phomopsis dianthina | Sacc. | 1915 |
| Phomopsis diaporthes-macrostomae | Traverso | 1906 |
| Phomopsis digitalis | D. Hawksw. & Punith. | 1973 |
| Phomopsis dioscoreae | Sacc. | 1913 |
| Phomopsis diospyri | (Sacc.) Traverso & Spessa | 1910 |
| Phomopsis diplodinoides | (Sacc.) Punith. | 1988 |
| Phomopsis dipsaci | (Cooke) Grove | 1917 |
| Phomopsis dominici | (Traverso) Sacc. & D. Sacc. | 1903 |
| Phomopsis dorycnii | Petr. | 1921 |
| Phomopsis dracaenae | V.P. Sahni | 1968 |
| Phomopsis dracaenicola | Z.D. Jiang, P.G. Xi & P.K. Chi | 2000 |
| Phomopsis duabangae | M.M. Xiang, Z.D. Jiang & P.K. Chi | 2003 |
| Phomopsis durandiana | (Sacc. & Roum.) Died. | 1911 |
| Phomopsis durionis | Syd. | 1932 |
| Phomopsis dysoxyli | (Sacc.) Petr. | 1957 |
| Phomopsis ebulina | (Sacc. & Schulzer) Grove | 1935 |
| Phomopsis echioidis | (Brunaud) Gonz. Frag. | 1917 |
| Phomopsis edgworthiae | (Sacc.) Grove | 1919 |
| Phomopsis effusa | (Roberge ex Desm.) Höhn. | 1918 |
| Phomopsis elaeagni | Sacc. | 1915 |
| Phomopsis elaeagnicola | C.Q. Chang, M.M. Xiang & P.K. Chi | 2005 |
| Phomopsis elaeidis | Punith. | 1974 |
| Phomopsis elasticae | Petr. | 1916 |
| Phomopsis elenkinii | Lebedeva | 1923 |
| Phomopsis elliptica | (Peck) Grove | 1935 |
| Phomopsis emicis | R.G. Shivas | 1992 |
| Phomopsis emmanuelii | Vegni | 1964 |
| Phomopsis endogena | (Speg.) Cif. | 1950 |
| Phomopsis ephedrae | Novoss. | 1936 |
| Phomopsis epicarpa | Sacc. | 1909 |
| Phomopsis epiglandula | (Tassi) Bond.-Mont. | 1936 |
| Phomopsis ericaceana | Fairm. | 1918 |
| Phomopsis erini | Sousa da Câmara | 1936 |
| Phomopsis eriobotryae | Curzi | 1927 |
| Phomopsis eriodendri | (Died.) Aa | 2002 |
| Phomopsis erythrinae | (Petch) Petr. | 1957 |
| Phomopsis erythroxyli | Novoss. | 1938 |
| Phomopsis escalloniae | Grove | 1935 |
| Phomopsis eucalypti | Zerova | 1940 |
| Phomopsis eugeniae | Shreem. | 1972 |
| Phomopsis eumorpha | Sacc. | 1917 |
| Phomopsis eupatoriicola | Petr. | 1922 |
| Phomopsis euphorbiae | (Sacc.) Traverso | 1906 |
| Phomopsis extorris | Sacc. | 1915 |
| Phomopsis exul | (Sacc.) Grove | 1917 |
| Phomopsis fabae | Ondřej | 1991 |
| Phomopsis fagopyri | Traverso & Spessa | 1910 |
| Phomopsis familiaris | (Sacc.) Gutner | 1933 |
| Phomopsis fatsiae-japonicae | Petr. | 1916 |
| Phomopsis ficina | Sacc. | 1915 |
| Phomopsis filicina | H.C. Greene | 1963 |
| Phomopsis filiformis | N.C. Mandal & M.K. Dasgupta | 1984 |
| Phomopsis firmianae | Kamal, P. Kumar & R.P. Singh | 1981 |
| Phomopsis fischeri-eduardi | Bubák | 1916 |
| Phomopsis flacourtiae | S.M. Singh | 1979 |
| Phomopsis flueckigeriae | (Gutner) Vanev & Aa | 2002 |
| Phomopsis foeniculi | Du Manoir & Vegh | 1981 |
| Phomopsis folliculicola | Punith. | 1974 |
| Phomopsis fontanesiae | Alcalde | 1952 |
| Phomopsis fragosoana | (Sousa da Câmara) Vanev & Aa | 2002 |
| Phomopsis fragosoi | Bubák | 1915 |
| Phomopsis francoae | Speg. | 1910 |
| Phomopsis fraterna | Fairm. | 1922 |
| Phomopsis fraxinellae | (Tassi) Petr. | 1992 |
| Phomopsis fuchsiae | (Brunaud) E.K. Cash | 1972 |
| Phomopsis furcraeae | Sacc. | 1906 |
| Phomopsis fusiformis | N.C. Mandal & M.K. Dasgupta | 1984 |
| Phomopsis garryae | Grove | 1922 |
| Phomopsis garugae | N.D. Sharma | 1982 |
| Phomopsis gasteriae | Sacc. | 1915 |
| Phomopsis genistae-tinctoriae | Petr. | 1917 |
| Phomopsis gevuinicola | (Speg.) Aa | 2002 |
| Phomopsis ginkgonis | Z.D. Jiang, C.Q. Chang & M.M. Xiang | 2007 |
| Phomopsis glandicola | (Lév.) Grove | 1917 |
| Phomopsis glaziovae | Bond.-Mont. | 1936 |
| Phomopsis gliricidiae | Syd. & P. Syd. | 1913 |
| Phomopsis glycines | Petr. | 1936 |
| Phomopsis gmelinae | Sankaran, Florence & J.K. Sharma | 1987 |
| Phomopsis gnomoniae | Petr. | 1923 |
| Phomopsis gomphocarpi | Sousa da Câmara | 1936 |
| Phomopsis gomphrenae | M.H. Li, Z.D. Jiang & P.K. Chi | 2004 |
| Phomopsis gorakhpurensis | Kamal, P. Kumar & R.P. Singh | 1981 |
| Phomopsis grabowskiae | Alcalde | 1952 |
| Phomopsis grewiae | (Died.) Aa | 2002 |
| Phomopsis grossulariae | Gutner | 1928 |
| Phomopsis guareae | (Henn.) Aa | 2002 |
| Phomopsis guiyan | Chuan F. Zhang & P.K. Chi | 1996 |
| Phomopsis guiyuan | C.F. Zhang & P.K. Chi | 2000 |
| Phomopsis gulabii | B. Lal & A. Arya | 1981 |
| Phomopsis gymnocladi | Byzova | 1968 |
| Phomopsis hakeae | Lebedeva | 1923 |
| Phomopsis halimii | Alcalde | 1945 |
| Phomopsis hameliae | Gonz. Frag. & Cif. | 1928 |
| Phomopsis heckeriae | (Henn.) Bat., R. Garnier & J.L. Bezerra | 1966 |
| Phomopsis hellebori | (Briard & Har.) Traverso | 1906 |
| Phomopsis heraclei | Lebedeva | 1933 |
| Phomopsis heritierae | Novoss. | 1936 |
| Phomopsis herminierae | (Cooke) Grove | 1917 |
| Phomopsis heteronema | Sacc. | 1913 |
| Phomopsis heterophragmatis | (Chona & Munjal) Vanev & Aa | 2002 |
| Phomopsis heveae | (Petch) Boedijn | 1929 |
| Phomopsis heveicola | Li Ma, M.M. Xiang & P.K. Chi | 2004 |
| Phomopsis hibisci | Dearn. | 1926 |
| Phomopsis hieracii | H.C. Greene | 1953 |
| Phomopsis hispaniolae | (Cif. & Gonz. Frag.) Vanev & Aa | 2002 |
| Phomopsis hollboelliae | Bond.-Mont. | 1936 |
| Phomopsis hranicensis | Petr. | 1921 |
| Phomopsis hughesii | N.D. Sharma | 1982 |
| Phomopsis hydnocarpi | S.M. Lin & P.K. Chi | 1992 |
| Phomopsis hydrangeae | M.T. Lucas & Sousa da Câmara | 1952 |
| Phomopsis hyperici | Grove | 1922 |
| Phomopsis hysteriola | (Sacc.) Grove | 1935 |
| Phomopsis ichnocarpi | Yesodh. & J.K. Sharma | 1987 |
| Phomopsis impatientis | Dearn. & House | 1921 |
| Phomopsis inclusa | Höhn. | 1920 |
| Phomopsis incommoda | (Trail) Grove | 1935 |
| Phomopsis inconstans | (Sacc.) Died. | 1912 |
| Phomopsis incrustans | Died. | 1911 |
| Phomopsis indica | Kamal, P. Kumar & R.P. Singh | 1981 |
| Phomopsis indigoferae | (Sacc.) Traverso & Spessa | 1910 |
| Phomopsis ingae-dulcis | (Died.) Aa | 2002 |
| Phomopsis inulina | (Sacc.) Petr. | 1929 |
| Phomopsis iochromatis | Gonz. Frag. | 1917 |
| Phomopsis ipomoeae | Petr. | 1922 |
| Phomopsis iridina | (Maire & Sacc.) M.T. Lucas & Sousa da Câmara | 1952 |
| Phomopsis iridis | (Cooke) D. Hawksw. & Punith. | 1975 |
| Phomopsis irregularis | (Died.) Petr. | 1921 |
| Phomopsis isorae | S.M. Singh | 1979 |
| Phomopsis iteae | (C.C. Chen) Vanev | 2002 |
| Phomopsis ixorae | Chowdhry | 1971 |
| Phomopsis jaczewskii | Panas. | 1929 |
| Phomopsis jambosae | Bond.-Mont. | 1936 |
| Phomopsis jasmini | Petr. | 1916 |
| Phomopsis jaunpurensis | R.C. Srivast. | 1980 |
| Phomopsis javanica | Uecker & D.A. Johnson | 1991 |
| Phomopsis juglandina | (Sacc.) Höhn. | 1906 |
| Phomopsis jurineae | Morochk. | 1933 |
| Phomopsis justiciae | (Tassi) M.T. Lucas & Sousa da Câmara | 1953 |
| Phomopsis kentrophylli | Ade | 1929 |
| Phomopsis kiggelariae | (Henn.) Died. | 1911 |
| Phomopsis kochiana | Gaja | 1912 |
| Phomopsis lactucae | (Sacc.) Bubák | 1905 |
| Phomopsis lagettae | Gutner | 1936 |
| Phomopsis lamii | Sacc. & D. Sacc. | 1905 |
| Phomopsis landolphiae | Novoss. | 1936 |
| Phomopsis lantanae | (M.E.A. Costa & Sousa da Câmara) B. Sutton | 1980 |
| Phomopsis lantanae-glutinosae | J.M. Pereira & R.W. Barreto | 2001 |
| Phomopsis lathyrina | (Sacc.) Grove | 1920 |
| Phomopsis latifolia | (Ellis & Everh.) Vanev & Aa | 2002 |
| Phomopsis lauri | Gutner | 1933 |
| Phomopsis laurina | Petr. | 1916 |
| Phomopsis lavandulae | (Gabotto) Cif. & Vegni | 1964 |
| Phomopsis lavaterae | (Westend.) Died. | 1921 |
| Phomopsis lavitskii | Zerova | 1940 |
| Phomopsis lebiseyi | (Sacc.) Died. | 1911 |
| Phomopsis lentisci | (Pass.) Sousa da Câmara | 1951 |
| Phomopsis lepidii | (Sacc.) Sousa da Câmara | 1949 |
| Phomopsis leptographa | (Sacc.) Petr. | 1922 |
| Phomopsis leucothoes | (Henn.) Died. | 1911 |
| Phomopsis liatridis | H.C. Greene | 1949 |
| Phomopsis libertii | M. Morelet | 1968 |
| Phomopsis ligulata | Grove | 1935 |
| Phomopsis ligustri-vulgaris | Petr. | 1921 |
| Phomopsis limonii | Vegh | 1994 |
| Phomopsis lirella | (Desm.) Grove | 1917 |
| Phomopsis lirellata | (Sacc.) Grove | 1935 |
| Phomopsis lirelliformis | (Sacc.) Bubák | 1915 |
| Phomopsis liriodendri | Grove | 1930 |
| Phomopsis lithocarpi | Y.H. Gao, W. Sun & L. Cai | 2013 |
| Phomopsis litoralis | Petr. | 1931 |
| Phomopsis litseae | Kamal & R.P. Singh | 1981 |
| Phomopsis lixivia | Höhn. | 1915 |
| Phomopsis lokoyae | G.G. Hahn | 1933 |
| Phomopsis longanae | P.K. Chi & Z.D. Jiang | 1992 |
| Phomopsis lonicerae | (Cooke ex Sacc.) Grove | 1917 |
| Phomopsis lophanthi | Sousa da Câmara | 1936 |
| Phomopsis loti | J. Upadhyay | 1966 |
| Phomopsis lucumae | Gutner | 1936 |
| Phomopsis lucumicola | Z.D. Jiang & P.K. Chi | 2000 |
| Phomopsis ludwigii | Petr. | 1923 |
| Phomopsis lueheae | Novoss. | 1936 |
| Phomopsis lumae | Syd. | 1928 |
| Phomopsis lusitanica | Sousa da Câmara | 1949 |
| Phomopsis lyonsiae | Petr. | 1957 |
| Phomopsis lysimachiae | (Cooke) Grove | 1917 |
| Phomopsis macadamii | Z.D. Jiang & P.K. Chi | 2000 |
| Phomopsis machaeriicola | Petr. | 1953 |
| Phomopsis macilenta | (Roberge ex Desm.) Petr. | 1929 |
| Phomopsis macrocarpae | P.G. Xi, Z.D. Jiang & P.K. Chi | 2000 |
| Phomopsis macrocollum | Alcalde | 1952 |
| Phomopsis macrospora | Tak. Kobay. & Chiba | 1961 |
| Phomopsis maculans | Curzi & Barbaini | 1927 |
| Phomopsis magnoliicola | (Syd. & P. Syd.) Died. | 1911 |
| Phomopsis magnoliina | C.Q. Chang, Z.D. Jiang & P.K. Chi | 2005 |
| Phomopsis magocsyana | Moesz | 1924 |
| Phomopsis mahoniae | Grove | 1930 |
| Phomopsis mahothocarpi | Y.H. Gao, W. Sun & L. Cai | 2013 |
| Phomopsis majuscula | Sacc. | 1906 |
| Phomopsis malvacearum | (Westend.) Died. | 1912 |
| Phomopsis mandevillae | M.E.A. Costa & Sousa da Câmara | 1952 |
| Phomopsis mangiferae | S. Ahmad | 1954 |
| Phomopsis mangrovei | K.D. Hyde | 1991 |
| Phomopsis manilkarae | R.K. Rajak & A.A.K. Chatterjee | 1984 |
| Phomopsis marrubii | (Durieu & Mont.) Grove | 1920 |
| Phomopsis marsdeniae | Petr. | 1931 |
| Phomopsis martyniae | Speg. | 1910 |
| Phomopsis mastoidea | M.E.A. Costa & Sousa da Câmara | 1953 |
| Phomopsis mauritiana | G.Q. Yuan & J.G. Wei | 2008 |
| Phomopsis mayteni | (Speg.) Aa | 2002 |
| Phomopsis mazzantioides | Petr. | 1921 |
| Phomopsis medinillae | Gutner | 1936 |
| Phomopsis mediterranea | Sacc. | 1913 |
| Phomopsis melaleuca | (Berk. & M.A. Curtis) Grove | 1919 |
| Phomopsis meliloti | Grove | 1930 |
| Phomopsis melocacticola | (Henn.) Died. | 1912 |
| Phomopsis menispermacearum | Gonz. Frag. | 1917 |
| Phomopsis menispermi | (Peck) Grove | 1917 |
| Phomopsis metrosideri | (H. Mori) Petr. | 1934 |
| Phomopsis micheliae | Sankaran, Florence & J.K. Sharma | 1987 |
| Phomopsis micheliicola | Z.D. Jiang, P.K. Chi & M.M. Xiang | 2002 |
| Phomopsis microspora | Kleb. | 1933 |
| Phomopsis millettiae | Swarup, L.S. Chauhan & Tripathi | 1966 |
| Phomopsis mimusopis | (Henn.) Aa | 2002 |
| Phomopsis mindoensis | Petr. | 1948 |
| Phomopsis minuscula | Grove | 1922 |
| Phomopsis missouriensis | Bubák | 1906 |
| Phomopsis mongolica | Petr. | 1934 |
| Phomopsis montanensis | G.G. Hahn | 1930 |
| Phomopsis morearum | (Brunaud) Curzi & Barbaini | 1927 |
| Phomopsis mori | Voglino | 1915 |
| Phomopsis morifolia | (Berl.) Petr. | 1927 |
| Phomopsis morphaea | Sacc. | 1884 |
| Phomopsis muelleri | (Cooke) Grove | 1917 |
| Phomopsis multipunctata | (Sacc.) Died. | 1911 |
| Phomopsis muscorum | Racov. | 1941 |
| Phomopsis musicola | (F. Stevens & E. Young) Punith. | 1975 |
| Phomopsis myopori | (Henn.) Died. | 1911 |
| Phomopsis myricae | Y.J. Huang & P.K. Chi | 2000 |
| Phomopsis myricariae | Syd. & P. Syd. | 1913 |
| Phomopsis myricina | Y.J. Huang & P.K. Chi | 2000 |
| Phomopsis myriosticta | Sacc. | 1914 |
| Phomopsis myrtilli | Petr. | 1924 |
| Phomopsis natsume | Hara | 1954 |
| Phomopsis neeae | (Bat. & Peres) Vanev & Aa | 2002 |
| Phomopsis nepetae | Gonz. Frag. | 1914 |
| Phomopsis nephelii | (Delacr.) Vanev & Aa | 2002 |
| Phomopsis nerii | Zerova | 1940 |
| Phomopsis neriicola | (Pat.) M.E.A. Costa & Sousa da Câmara | 1952 |
| Phomopsis nicotianae | Fairm. | 1923 |
| Phomopsis nidulans | (Grognot ex Sacc.) Höhn. | 1915 |
| Phomopsis nitidula | (Sacc.) Grove | 1917 |
| Phomopsis nivea | (Syd. & P. Syd.) Aa | 2002 |
| Phomopsis nymphaeae | Nag Raj & Ponnappa | 1970 |
| Phomopsis oblita | Sacc. | 1910 |
| Phomopsis oemanthi | Dzhalag. | 1965 |
| Phomopsis oenocarpi | Bat., J.L. Bezerra & J.E.W. Castro | 1964 |
| Phomopsis oenocarpicola | Bat. & R. Garnier | 1966 |
| Phomopsis oenotherae | (Dearn.) Petr. | 1929 |
| Phomopsis oleariae | Grove | 1922 |
| Phomopsis olisipponensis | (Sousa da Câmara) Sousa da Câmara | 1949 |
| Phomopsis oliveirana | Dias & Teixeira | 1963 |
| Phomopsis oncostoma | (Thüm.) Höhn. | 1917 |
| Phomopsis ononidicola | (Hollós) Moesz | 1930 |
| Phomopsis oppilata | (Fr.) Petr. | 1921 |
| Phomopsis opulana | Sacc. | 1913 |
| Phomopsis orchidophila | E.K. Cash & A.M.J. Watson | 1955 |
| Phomopsis oreodaphnes | (Henn.) Aa | 2002 |
| Phomopsis orobanches | Grove | 1933 |
| Phomopsis orysopsidis | M.T. Lucas & Sousa da Câmara | 1955 |
| Phomopsis oryzae | Punith. | 1975 |
| Phomopsis oryzae-sativae | Punith. | 1980 |
| Phomopsis osmanthi | Dzhalag. | 1965 |
| Phomopsis osyridis | Bubák | 1906 |
| Phomopsis ougeiniae | R.K. Verma, Soni & N. Sharma | 2008 |
| Phomopsis oxalina | (Ellis & Everh.) Syd. | 1930 |
| Phomopsis oxydendri | (Ellis & Everh.) Aa | 2002 |
| Phomopsis oxyspora | Petr. | 1953 |
| Phomopsis padina | (Sacc.) Died. | 1912 |
| Phomopsis pallida | (Fuckel) Sacc. & D. Sacc. | 1906 |
| Phomopsis pandani | Died. | 1916 |
| Phomopsis papayae | Gonz. Frag. & Cif. | 1926 |
| Phomopsis parabolica | Petr. | 1927 |
| Phomopsis pardalota | Died. | 1912 |
| Phomopsis parrotiae | Ratiani | 1969 |
| Phomopsis paspali | Deshmukh, Kanitkar & G.S. Pendse | 1975 |
| Phomopsis passiflorae | J.F. Lue & P.K. Chi | 1992 |
| Phomopsis paui | Gonz. Frag. | 1914 |
| Phomopsis pavgii | D.D. Shukla, V.N. Pathak & M. Rao | 1970 |
| Phomopsis pavoniae | Novoss. | 1936 |
| Phomopsis pedilanthi | B. Lal & A. Arya | 1982 |
| Phomopsis pehenningsii | N.D. Sharma | 1982 |
| Phomopsis pelargonii | Vörös | 1959 |
| Phomopsis pergulariae | Kamal, P. Kumar & R.P. Singh | 1981 |
| Phomopsis perniciosa | Grove | 1935 |
| Phomopsis petersii | Died. | 1911 |
| Phomopsis petiolorum | (Desm.) Grove | 1917 |
| Phomopsis phellodendri | Nann. | 1932 |
| Phomopsis philodendri | Z.D. Jiang, X.H. Zheng & P.K. Chi | 2000 |
| Phomopsis phlyctaenoides | (Berk. & M.A. Curtis) Höhn. | 1916 |
| Phomopsis phormiicola | Sacc. | 1915 |
| Phomopsis phyllanthi | Punith. | 1975 |
| Phomopsis phyllochlamydis | Novoss. | 1936 |
| Phomopsis phyllophila | Petr. | 1920 |
| Phomopsis phyteumatis | Petr. | 1922 |
| Phomopsis phytolaccae | (Berk. & M.A. Curtis) Grove | 1917 |
| Phomopsis pilocarpicola | (Sousa da Câmara) Vanev & Aa | 2002 |
| Phomopsis pimpinellae | (Ellis) H.C. Greene | 1953 |
| Phomopsis pinophylla | Höhn. | 1918 |
| Phomopsis pircuniae | Sacc. | 1915 |
| Phomopsis pisicola | Petr. & Cif. | 1930 |
| Phomopsis pitcairniae | Bond.-Mont. | 1936 |
| Phomopsis pittospori | (Cooke & Harkn.) Grove | 1919 |
| Phomopsis plantaginis | Kurbans. | 1980 |
| Phomopsis platanoidis | (Cooke) Died. | 1912 |
| Phomopsis platycerii | (Tassi) Aa | 2002 |
| Phomopsis pleromatis | (Speg.) Aa | 2002 |
| Phomopsis plumeriae | N.D. Sharma | 1975 |
| Phomopsis podalyriae | (Henn.) Died. | 1911 |
| Phomopsis podocarpi | C.Q. Chang, Z.D. Jiang & P.K. Chi | 2005 |
| Phomopsis podophylli | (Cooke) Grove | 1917 |
| Phomopsis polyalthiae | Shreem. | 1984 |
| Phomopsis polygalae-myrtifoliae | (Henn.) Dias & Sousa da Câmara | 1952 |
| Phomopsis polygonorum | (Cooke) Grove | 1917 |
| Phomopsis populina | Voglino | 1909 |
| Phomopsis porteri | A. Funk | 1975 |
| Phomopsis praetervisa | Grove | 1919 |
| Phomopsis prosopidicola | (Speg.) Aa | 2002 |
| Phomopsis pruni | (Ellis & Dearn.) Wehm. | 1926 |
| Phomopsis prunorum | (Cooke) Grove | 1917 |
| Phomopsis psidii | Nag Raj & Ponnappa | 1974 |
| Phomopsis psoraleae | Bubák | 1906 |
| Phomopsis pteleae | Panas. | 1938 |
| Phomopsis pterocariicola | Li Ma, Z.D. Jiang & P.K. Chi | 2004 |
| Phomopsis pterospermi | Bond.-Mont. | 1936 |
| Phomopsis punicae | C.W. Guo & P.K. Chi | 2000 |
| Phomopsis punicicola | C.Q. Chang, Z.D. Jiang & P.K. Chi | 2005 |
| Phomopsis putranjivae | Kamal, P. Kumar & R.P. Singh | 1981 |
| Phomopsis pyrorum | Sacc. & Trotter | 1920 |
| Phomopsis pyrrhocystis | Petr. | 1920 |
| Phomopsis quercicola | Moesz | 1921 |
| Phomopsis quercina | (Sacc.) Höhn. ex Died. | 1911 |
| Phomopsis quercus | (Sacc. & Speg.) Curzi & Barbaini | 1927 |
| Phomopsis radula | (Berk. & Broome) Grove | 1917 |
| Phomopsis ramealis | (Desm.) Died. | 1911 |
| Phomopsis ramicola | (Petch) Aa | 2002 |
| Phomopsis ranojevicii | Bubák | 1910 |
| Phomopsis rapaneae | (Speg.) Aa | 2002 |
| Phomopsis rhagadioli | Novoss. | 1938 |
| Phomopsis rhaphidis | Gonz. Frag. | 1917 |
| Phomopsis rhaphithamni | (Speg.) Aa | 2002 |
| Phomopsis rhapidis | Gonz. Frag. | 1917 |
| Phomopsis rhinanthi | (Sommerf.) Arx | 1957 |
| Phomopsis rhizophorae | Bat. & H. Maia | 1955 |
| Phomopsis rhododendri | Z.D. Jiang, M.M. Xiang & P.K. Chi | 2003 |
| Phomopsis rhododendricola | Li Ma, M.M. Xiang & P.K. Chi | 2004 |
| Phomopsis rhodophila | (Sacc.) N.F. Buchw. | 1958 |
| Phomopsis rhodotypi | (Henn.) Died. | 1911 |
| Phomopsis rhynchosiae | Novoss. | 1936 |
| Phomopsis ribatejana | Sousa da Câmara | 1948 |
| Phomopsis ricinella | Petr. | 1916 |
| Phomopsis robergeana | (Sacc.) Died. | 1911 |
| Phomopsis rojana | Gaja | 1911 |
| Phomopsis rosae | (Schulzer & Sacc.) Died. | 1911 |
| Phomopsis rubiseda | Fairm. | 1922 |
| Phomopsis rudgeae | Novoss. | 1936 |
| Phomopsis rusci | (Westend.) Grove | 1935 |
| Phomopsis rutae | (Henn.) Died. | 1915 |
| Phomopsis sabaleos | (Ces.) Bond.-Mont. | 1936 |
| Phomopsis sabiae | Gutner | 1936 |
| Phomopsis sacchari | Punith. | 1975 |
| Phomopsis salicina | (Westend.) Died. | 1911 |
| Phomopsis salmalica | A.H. Khan | 1961 |
| Phomopsis salviae | (Brunaud) Traverso | 1915 |
| Phomopsis sapindacearum | Bond.-Mont. | 1936 |
| Phomopsis sapindi | (Pat.) Sacc. | 1915 |
| Phomopsis sapotae | B. Lal & T.R.N. Rai | 1980 |
| Phomopsis saxegothaeae | Syd. | 1928 |
| Phomopsis scabella | (Penz.) Curzi | 1925 |
| Phomopsis schefflerae | P.G. Xi, P.K. Chi & Z.D. Jiang | 2003 |
| Phomopsis schlerotioides | H.A. Kerst. | 1967 |
| Phomopsis schoenocauli | Syd. | 1930 |
| Phomopsis sclareae | Sarwar | 1977 |
| Phomopsis scobinella | Sacc. & D. Sacc. | 1906 |
| Phomopsis scutellariae | Bond.-Mont. | 1945 |
| Phomopsis scutiae | (Speg.) Aa | 2002 |
| Phomopsis sedi | Punith. | 1974 |
| Phomopsis serebrianikowii | (Bubák) Höhn. | 1917 |
| Phomopsis serjaniae | Gutner | 1936 |
| Phomopsis seseli | Lobik | 1928 |
| Phomopsis sidae | Traverso | 1915 |
| Phomopsis silenes | D. Hawksw. & Punith. | 1975 |
| Phomopsis similis | Bubák | 1915 |
| Phomopsis siphonodontis | (Sacc.) Aa & Vanev | 2002 |
| Phomopsis skimmiae | Grove | 1933 |
| Phomopsis smilacina | Gonz. Frag. | 1916 |
| Phomopsis smilacis | J.F. Lue & P.K. Chi | 1994 |
| Phomopsis smyrnii | (Sousa da Câmara) M.T. Lucas & Sousa da Câmara | 1955 |
| Phomopsis solani | Grove | 1917 |
| Phomopsis sorbicola | Grove | 1930 |
| Phomopsis sorbina | Sacc. | 1915 |
| Phomopsis sorghi | Morochk. | 1933 |
| Phomopsis sorghicola | Punith. | 1975 |
| Phomopsis spartii | (Sacc.) Died. | 1911 |
| Phomopsis spiraeae | (Desm.) Grove | 1920 |
| Phomopsis spironemae | Gonz. Frag. | 1917 |
| Phomopsis staphyleae | Höhn. | 1916 |
| Phomopsis stellariae | (L.A. Kirchn.) Petr. | 1921 |
| Phomopsis stenocarpi | (Tassi) Gutner | 1936 |
| Phomopsis sterculiae | S.M. Lin & P.K. Chi | 1992 |
| Phomopsis sterculicola | Z.D. Jiang & P.K. Chi | 2000 |
| Phomopsis stewartii | Peck | 1910 |
| Phomopsis stictostoma | (Grove) Grove | 1923 |
| Phomopsis stillingiae | (Ellis & Everh.) Aa | 2002 |
| Phomopsis striiformis | (Durieu & Mont.) Grove | 1917 |
| Phomopsis stromatigena | Maire | 1917 |
| Phomopsis subnervisequa | (Desm.) Höhn. | 1918 |
| Phomopsis swainsonae | (Henn.) Died. | 1911 |
| Phomopsis symploci | Petr. | 1940 |
| Phomopsis syncarpiae | Gutner | 1936 |
| Phomopsis syngenesia | (Brunaud) Höhn. | 1917 |
| Phomopsis syzigii | Z.D. Jiang & P.K. Chi | 2000 |
| Phomopsis syzygiicola | Li Ma, Z.D. Jiang & P.K. Chi | 2004 |
| Phomopsis tabernaemontanae | Ponnappa & Nag Raj | 1974 |
| Phomopsis tamaricaria | (Sacc.) Grove | 1935 |
| Phomopsis tamarindi | A. Arya, C. Arya, R. Agarwal & B. Lal | 1999 |
| Phomopsis tami | (Lambotte & Fautrey) Petr. | 1921 |
| Phomopsis tecomae | (Sacc.) Traverso & Spessa | 1910 |
| Phomopsis tectonae | D.P. Tiwari, R.C. Rajak & Nikhra | 1981 |
| Phomopsis templetoniae | (Henn.) Died. | 1911 |
| Phomopsis tenuipes | (Tassi) Aa | 2002 |
| Phomopsis tephrosiae | Chowdhry | 1967 |
| Phomopsis teramni | Hasija | 1963 |
| Phomopsis terminaliae | (Henn.) B. Sutton | 1980 |
| Phomopsis ternstroemiae | Y.H. Gao, W. Sun & L. Cai | 2013 |
| Phomopsis tezpatae | S.M. Singh | 1979 |
| Phomopsis thalictri | H.C. Greene | 1963 |
| Phomopsis thalictrina | (Sacc. & Malbr.) Died. | 1911 |
| Phomopsis theicola | Curzi | 1926 |
| Phomopsis theobromae | (J.V. Almeida & Sousa da Câmara) Bond.-Mont. | 1936 |
| Phomopsis thermopsidis | N.F. Buchw. | 1958 |
| Phomopsis thespesiae | Luke & C.N. Reddy | 1979 |
| Phomopsis thevetiae | M.M. Xiang, Z.D. Jiang & P.K. Chi | 2003 |
| Phomopsis thujae | Died. | 1912 |
| Phomopsis tinea | (Sacc.) Höhn. | 1911 |
| Phomopsis tipuanae | (Tassi) M.T. Lucas & Sousa da Câmara | 1952 |
| Phomopsis tirrenica | Moriondo | 1961 |
| Phomopsis tomentosae | Purkay. & Mallik | 1976 |
| Phomopsis tommaseana | Gaja | 1912 |
| Phomopsis toxicodendri | (Henn.) Died. | 1911 |
| Phomopsis trachelii | Gonz. Frag. | 1917 |
| Phomopsis tragopogonis | Sandu & Mítítíuc | 1971 |
| Phomopsis trematis | Ponnappa & Nag Raj | 1974 |
| Phomopsis trichiliae | Petr. & Cif. | 1932 |
| Phomopsis trichosanthis | Bond.-Mont. | 1938 |
| Phomopsis tritici | Punith. | 1980 |
| Phomopsis trochodendri | (J.V. Almeida & Sousa da Câmara) Vanev | 2002 |
| Phomopsis trollii | Fairm. | 1922 |
| Phomopsis tropaeoli | Punith. & Spooner | 1999 |
| Phomopsis truncicola | Miura | 1928 |
| Phomopsis ulmicola | Petr. | 1921 |
| Phomopsis umbrina | (Bonord.) Bubák | 1916 |
| Phomopsis urticicola | Traverso & Spessa | 1910 |
| Phomopsis variabilis | (Penz. & Sacc.) Höhn. | 1920 |
| Phomopsis variosporum | J.K. Sharma, C.N. Mohanan & Florence | 1985 |
| Phomopsis venenosa | (Sacc.) Traverso & Spessa | 1910 |
| Phomopsis verbasci | D. Hawksw. & Punith. | 1973 |
| Phomopsis veronicae-speciosae | (Henn.) Died. | 1911 |
| Phomopsis viciae | Bubák | 1915 |
| Phomopsis vicina | (Desm. ex Sacc.) Grove | 1917 |
| Phomopsis viennot-bourginii | Moesz | 1938 |
| Phomopsis vignae | (Speg.) Aa & Vanev | 2002 |
| Phomopsis villaresiae | Gutner | 1933 |
| Phomopsis vincentiana | (Speg.) M.T. Lucas & Sousa da Câmara | 1954 |
| Phomopsis viridarii | (Sacc.) Traverso & Spessa | 1913 |
| Phomopsis vismiae | Petr. | 1950 |
| Phomopsis viterbensis | Camici | 1948 |
| Phomopsis viticis | Urries | 1952 |
| Phomopsis voitiae | Ohl | 1915 |
| Phomopsis wampi | C.F. Zhang & P.K. Chi | 2000 |
| Phomopsis xanthii | Vörös | 1959 |
| Phomopsis xylocarpi | Purkay. & A.K. Pal bis | 1996 |
| Phomopsis yuccae | V.P. Sahni | 1968 |
| Phomopsis zeicola | M.E.A. Costa & Sousa da Câmara | 1954 |
| Phomopsis zelkovae | Ratiani | 1969 |
| Phomopsis zijingensis | Y.J. Huang & P.K. Chi | 2000 |
| Phomopsis ziziphicola | C.Q. Chang, Z.D. Jiang & P.K. Chi | 2005 |
| Phomopsis ziziphina | Ponnappa | 1971 |
Bronnen, noten en/of referenties
- (en) Index Fungorum